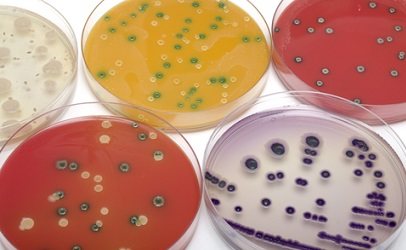
Salmonella Testing Salmonella Testing

How to plan for USDA HACCP validation: Q&A with food safety consultants

Earlier this year, the USDA Food Safety Inspection Service (FSIS) released the final requirements for Hazard Analysis & Critical Control Points (HACCP) systems validations. The new HACCP regulations go into effect January 4 for large establishments (500+ employees), then in April for smaller (<500 employees). Will your company be ready in time to avoid non-compliance and enforcement actions?
Alchemy asked two food industry consultants to address a few questions from food industry professionals like you.
What is FSIS?
Dr. Amit Morey: That’s the Food Safety Inspection Service, which is the division of the USDA that completes the inspection in meat and poultry establishments.
What penalty will large and small food manufacturers face if they do not meet the January 4th and April 4th, 2016 deadline?
Dr. Amit Morey: The Food Safety Inspection Service (FSIS) will begin their verification processes on the January and the April dates identified. In the event that companies have not properly validated their HACCP system, penalties are assessed depending on the severity of the non-compliance. One of two things could happen:
1. For minor violations, the USDA could issue a non-compliance report that documents a deficiency. The report will show that you failed to meet the regulatory requirements cited in 417.4 of the USDA regulations for verification, validation, and reassessments. Altternatively, the report may show a failure to meet section 417.5, which is the section that requires you to maintain records of these validation activities. That is one example of potential enforcement.
2. If a more serious situation occurs that implicates a food safety issue, and/or your facility can’t prove that you are not producing an adulterated product then the USDA could take a more significant enforcement action. This is called a notice of intended enforcement. The agency would issue a letter giving the facility three days to respond to that letter. In the response, facilities should cite what corrective actions are going to be taken.
The USDA will make a decision whether or not the response will be accepted, and put into abeyance. If the response plan is not accepted then the company could face the possibility of withdrawal of that inspection, and be shut down until they can submit acceptable corrective actions.
Don’t wait too long to comply with the requirements.
{{cta(‘fb13e38d-7c79-4d57-892e-7562ea19818f’)}}
Photo: Food Safety News
What indicator organism can be used in place of salmonella for FSIS compliant microbial testing?
Dr. Amit Morey: Some companies have used E. Coli as one of the indicator organisms in the past. I think soon it’s going to change.
Dr. John Marcy and I are holding a round table conference at the University of Arkansas with USDA officials asking the exact same question. The consensus is, E. Coli might not be the best indicator organism to use all of the time. I don’t have an exact answer for you, but it will probably come in the near future.
Does testing include ingredients, raw materials, or spices as well as finished product?
Jeff Chilton: Ingredients are often validated with Certificates of Analysis (COA’s) provided by suppliers demonstrating control of biological hazards. In addition, a Continuing Letter of Guarantee should be provided by the supplier.
Often ingredients that can be used can be validated with the FSIS directive 7120.1, which is related to safe and suitable ingredients. That’s a listing of all the ingredients that are acceptable for us, and the concentration level of those various types of ingredients.
So, if you’re using ingredients in compliance with what’s listed in that directive 7120.1, then that would be considered to be an accurate supporting documentation for the validation of that ingredient.
If your company has a substantial HACCP program, what changes need to occur to meet all of the requirements for HARPC?
Jeff Chilton: The HARPC requirements will apply to the FDA regulated establishments, and will not apply to USDA related establishments.
HARPC stands for the hazard, analysis, and risk based preventative controls. So, it’s a little bit different type of food safety plan than what most USDA inspected establishments are familiar with. There will be additional emphasis placed on prerequisite programs, which are the preventative controls that are cited in the HACCP plans and the hazard analysis itself.
There are additional types of hazards that will have to be taken into consideration that have not been addressed in USDA HACCP plans. Things such as potential and intentional adulteration, sabotage of products, and even radiological type hazards should be addressed.
So, there’s quite a different for HARPC compared to HACCP. It depends on whether you’re operating in a USDA establishment versus an FDA establishment as to which one of those regulations will be applicable.
Dr. Amit Morey: In HARPC, you’re again looking at preventive controls, so it is up to you. In the HARPC regulation it clearly states that you develop a plan to really identify where the risk lies.
It can be sanitation, it can be an allergen control program, it can be equipment – it can be anything. It is up to you, it is up to our industry, and each individual company to figure out where those hazards are and try to eliminate any risks.
If a facility is neither FDA nor USDA regulated, but the company has a HACCP plan because of customer requirements, should the existing HACCP program change?
Jeff Chilton: Very potentially. It depends upon the GFSI standards a company is certified under such as Safe Quality Food (SQF), or British Retail Consortium (BRC), or the FSSC 22000 standard. Each of those three standards have slightly different requirements and expectations related to their HACCP.
Companies would need to look at what their own customer audit requirements are, and the audit standards that they have to meet to satisfy those customers.

Photo: Dakota Prairie Flour Mill – Enterprise Electric
Would flour mills fall under the HACCP or HARPC plan?
Jeff Chilton: Flour mills would fall under the HARPC plan for an FDA regulated establishment.
Is there anything specific that food packaging manufacturers need to do?
Jeff Chilton: The packaging industry is very interesting, and certainly getting a lot more attention than it has had in the past. Many food packaging companies have already achieved GFSI certification under SQF, BRC, and FSSC 22000.
Food packaging companies need to be looking at what they have to do to meet the customer audit requirements and which of the GFSI standards they should become certified under.
That’s certainly one of the big steps that the packaging industry needs to comply with in the future. The food packaging industry also has to comply with the general FDA requirements that are identified under 21 CFR 110 for good manufacturing practices.
There are also specific packaging requirements under 21 CFR 173. There are certainly regulatory requirements associated with FDA standards that packaging companies have to meet. That’s in addition to becoming ready for GFSI certification standards if a company has not yet been certified.
About the consultants:
Dr. Amit Morey
Dr. Morey is an Applied Scientist and subject matter expert on food safety and shelf life. He works with food processing plants and their management to resolve issues raised by the USDA/FDA and their clients. Formerly the Principal Scientist, Special Projects at Food Safety Net Services, Dr. Morey is currently the Founder and President of I.D.E.A. Food Industry Consultants, Inc.
Jeff Chilton, Vice President, Professional Services, Alchemy
Jeff has over 30 years of experience in the food industry, specializing in food safety, quality assurance, and plant management. He was President of Chilton Consulting Group for 16 years assisting clients achieve GFSI certification under the SQF, BRC, or FSSC 22000 standards.



